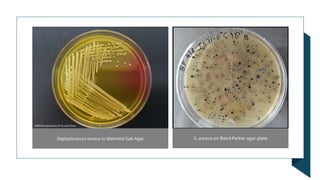
Staphylococcus aureus in Mannitol Salt Agar S. aureus on Baird-Parker agar plate
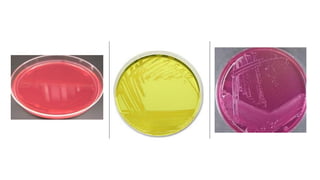

Staphylococcus aureus is a gram-positive bacterium that can cause food poisoning through exotoxins resistant to heat and enzymes, leading to gastrointestinal illness. It is commonly transmitted via contaminated food, often due to poor hygiene of food handlers, and can tolerate high salt levels and low water activity, favoring its growth in processed foods. To prevent contamination, strict hygiene practices, temperature control, and food safety management systems are essential.